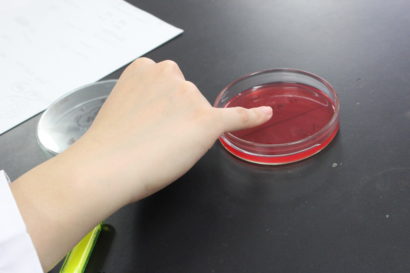
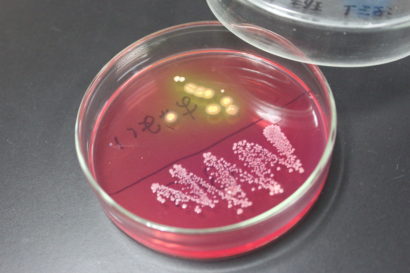

悠久山 春のタマゴ祭り
- お知らせ
- 授業の様子
- 調理専攻科
西洋料理の実習では、パスタや肉料理、魚料理といろいろ作りますが、卵料理をたくさん作る日というのがあります(●´ω`●)ワクワク♪今回はゆで卵、目玉焼き、炒り卵、湯落とし卵、揚げ卵、オムレツ...
こんにちは(^o^)毎日暑い日が続いていますが、みなさん元気でお過ごしでしょうか??
本日は、栄養士科2年生の授業「食品衛生学実験」の様子をお伝えします!
栄養士は、対象者へ美味しい食事を届けるために、調理技術だけではなく、
他にもさまざまな知識が必要となります!
「食品衛生学実験」は、細菌を観察し、細菌の特徴を学びながら食中毒等の事故を
予防する方法を考えていきます。
今回紹介する実験は、調理時の汚染を防ぐということを目的として、
「黄色ブドウ球菌の保菌調査」を実施した時の様子です。
みんなの皮膚には、どのくらいの黄色ブドウ球菌が常在しているのでしょうか!!
1日目は、細菌を培養するための準備を実施します。
細菌の培養には細菌の発育に必要な環境を整えなければなりません。
そのため、観察する細菌の種類によって培地の種類も異なります。
今回は、卵黄加マンニット食塩培地を作成しています!

培地が出来上がったら、こめかみや首、鼻等の調理時に指で触れそうな部位を
学生1人1人が拭き取って、培地に塗っていきます!
「35~37℃、48時間」という細菌にとって育ちやすい環境で培養し、
結果は2日後・・・・・
2日目は観察!学生はみんなドキドキです(^_^;)
ある班での結果です!な、なんと、こめかみから黄色ブドウ球菌が出現しました!!
黄色の方が黄色ブドウ球菌です。
その後は細菌を染色し、顕微鏡で観察をします!
黄色ブドウ球菌は、顕微鏡で観察するとブドウの房のように複数の細菌が集団を
形成しています。白色の細菌からは、表皮ブドウ球菌や乳酸菌が観察できました。

最後は、各班で結果をまとめて発表をします!
自分が集団給食施設の栄養士として従業員に衛生指導を行うつもりで、
クラスのみんなの前で発表をしました!(^^)!
黒板には、黄色ブドウ球菌の割合、その他観察できた細菌の種類について
班ごとにまとめてあります!

「汗をかいても手で顔を拭かないように気をつけましょう!」
「細菌は、全て皮膚についているもののため、調理作業前は手指の洗浄をしっかり
行いましょう!」
「汗がついた衣類はしっかり洗浄しましょう!」
・・・・・さまざまな指導がありましたが、衛生管理のためには全て重要なことです!
黄色ブドウ球菌は、人の体でも皮膚や髪の毛、鼻等多くの場所に生存しているのです(+_+)
黄色ブドウ球菌によって食品が汚染されると増殖過程において毒素を産生し、結果として
食中毒が引き起こされてしまいます。
今回の実験では、細菌はどこにどれくらいの割合でついているのか、
食中毒を引き起こさないためにはどうしたらよいか、ということを2日間で学ぶことができましたね!!
給食や食品製造の現場で衛生指導と教育ができる栄養士を目指して
今後も頑張っていきましょう(*^^)v☆
学生は夏休みに入りました!
夏休み期間は、オープンキャンパスがたくさん開催される予定です♪
少しでも興味がある方は、ぜひ遊びに来てくださいね(^O^)
↓オープンキャンパスの日程は↓
【こちら】
最新記事